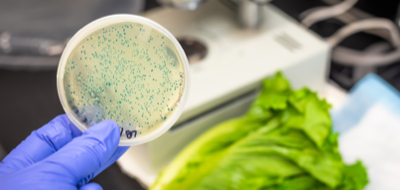

INSURANCE FOR BUSINESS
Your business faces risks every day. That's why Prime Insurance offers a wide range of specialized products
- both broad and specialized
- to help protect your property, employees, customers and assets
Where we operate.
Lorem Ipsum is simply dummy text of the printing and typesetting industry.
Insurance Solutions by Industry

Contractors
Selective makes finding the right commercial contractors insurance easy. Learn how we can help you protect your business with broad and flexible insurance for contractors that meets your unique needs.

Private Schools
As an educator, you serve an important role in our communities and need private school insurance to match. Selective offers business insurance solutions that can help you protect your educational organization and those in your care.

Manufacturing
Manufacturing risks come in all shapes and sizes, and Prime Insurance’s manufacturers insurance provides the broad and flexible coverage necessary to protect your unique business. From product liability to manufacturer’s errors and omissions insurance, we’ve got what you need.

Auto care and services
From auto repair shops to car service centers, our team of auto care insurance professionals can help you get the specialized coverage you need to protect your auto care business.

Professional Offices
Professional offices have particular risks that aren’t always covered by standard business insurance. Learn how our professional offices insurance offers comprehensive protection for unique businesses like yours.

Technology
You need technology insurance that can keep up with the ever-changing state of the industry. Selective’s broad definitions in the technology errors and omissions policy can prevent your coverage from being outdated before the next software update.
Insurance Coverage for Your Business

Business Owners Policy
If you’re looking for business owners insurance but don’t know where to start, we have the answer. Our Business Owners Policy (BOP) combines general liability and property coverage into one, affordable insurance package.

Cyber Liability Insurance
Now more than ever, you need cyber liability insurance for your business. Our all-in-one cybersecurity solution offers cyber risk management against a variety of threats.
Product Recall
If your company manufactures or distributes items, you need product recall insurance for your business. Learn how this business insurance solution can help minimize financial damages resulting from a product recall.

Management Liability
Your company and employees are exposed to a variety of litigation risks. Find out how management liability insurance was designed to help you defend against these claims.

Errors & Omissions
Certain industries like manufacturing and contracting face an increased risk of accidents, which requires an increased level of coverage. Protect your unique company and employees with our essential errors and omissions insurance.

Commercial Flood
Flooding can happen anytime, anywhere, putting your business at risk. Since flood insurance isn’t included with standard policies, learn how you can protect your unique business with commercial flood insurance from the National Flood Insurance Program (NFIP).

